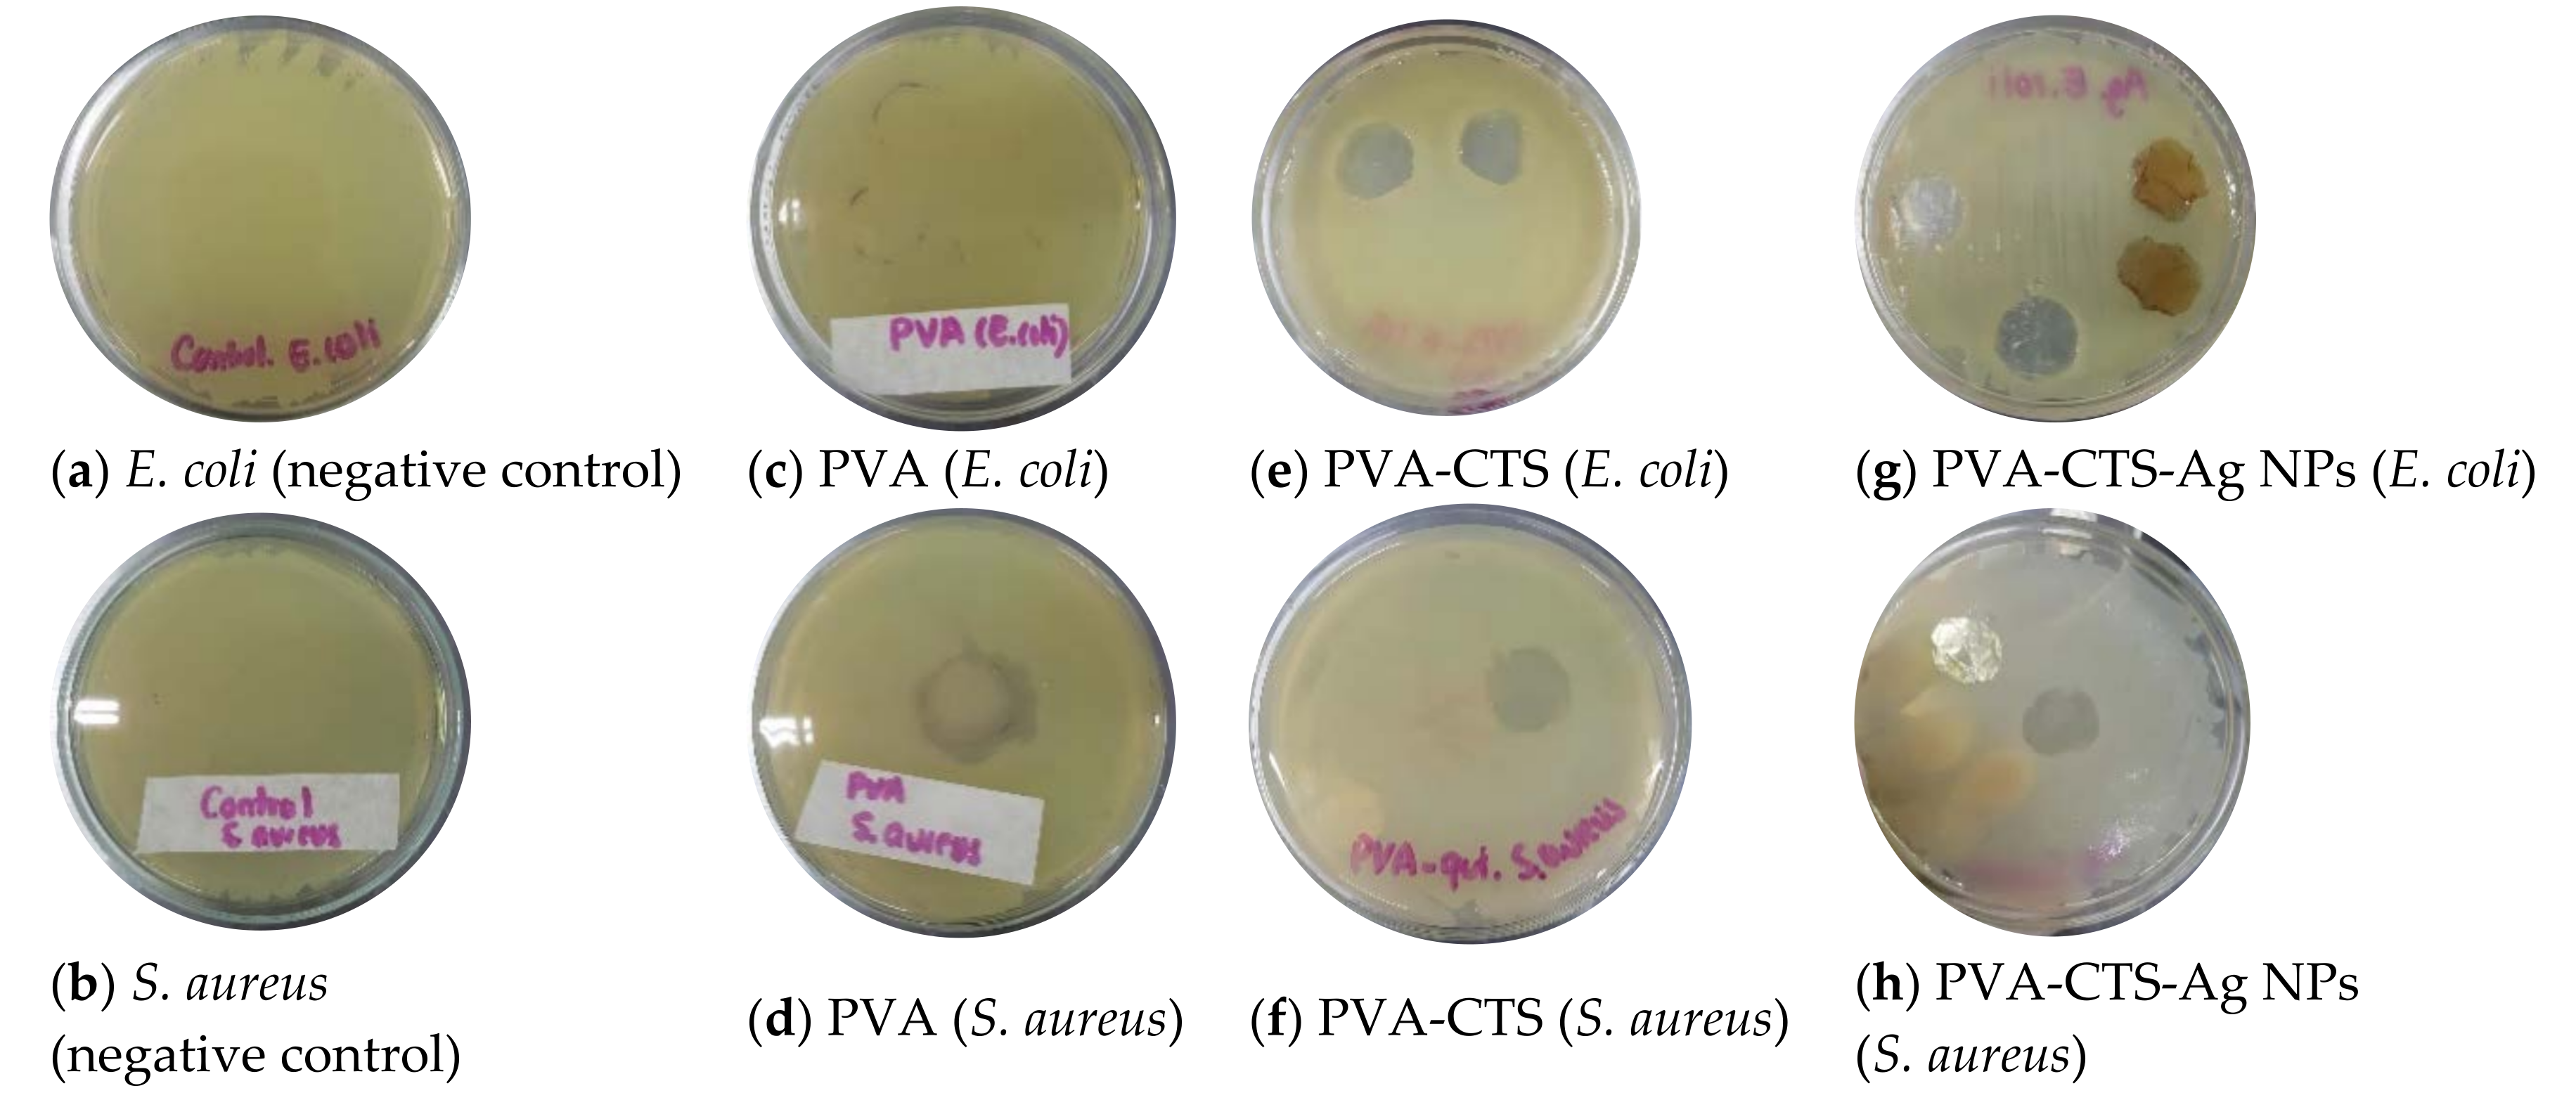
Polymers 14 00674 g009

In Situ Growth of Silver Nanoparticles on Chitosan Matrix for the Synthesis of Hybrid Electrospun Fibers: Analysis of Microstructural and Mechanical Properties
Abstract
:1. Introduction
2. Materials and Methods
2.1. Reagents and Materials
2.2. CTS-Ag NPs In Situ Synthesis
2.3. Preparation of PVA-CTS and PVA-CTS-Ag NPs Electrospun Fibers
2.4. Characterization of Nanostructures and Electrospun Fibers
3. Results
3.1. Characterization of the CTS-Ag NPs Compounds
3.2. Characterization of PVA-CTS and PVA-CTS-Ag NPs Electrospun Fibers
3.2.1. Structural Properties
3.2.2. Morphological and Microstructural Analysis
3.2.3. Mechanical Properties
3.2.4. Antibacterial Assessment
4. Conclusions and Future Perspectives
Author Contributions
Funding
Institutional Review Board Statement
Informed Consent Statement
Data Availability Statement
Acknowledgments
Conflicts of Interest
References
- Subbiah, T.; Bhat, G.S.; Tock, R.W.; Parameswaran, S.; Ramkumar, S.S. Electrospinning of nanofibers. J. Appl. Polym. Sci. 2005, 96, 557–569. [Google Scholar] [CrossRef]
- Haider, A.; Haider, S.; Kang, I.-K. A comprehensive review summarizing the effect of electrospinning parameters and potential applications of nanofibers in biomedical and biotechnology. Arab. J. Chem. 2018, 11, 1165–1188. [Google Scholar] [CrossRef]
- Miguel, S.P.; Figueira, D.R.; Simões, D.; Ribeiro, M.P.; Coutinho, P.; Ferreira, P.; Correia, I.J. Electrospun polymeric nanofibres as wound dressings: A review. Colloids Surf. B 2018, 169, 60–71. [Google Scholar] [CrossRef] [PubMed]
- Reneker, D.H.; Yarin, A.L. Electrospinning jets and polymer nanofibers. Polymer 2008, 49, 2387–2425. [Google Scholar] [CrossRef] [Green Version]
- Beck, R.J.; Zhao, Y.; Fong, H.; Menkhaus, T.J. Electrospun lignin carbon nanofiber membranes with large pores for highly efficient adsorptive water treatment applications. J. Water Process. Eng. 2017, 16, 240–248. [Google Scholar] [CrossRef]
- Yaqoob, A.A.; Ahmad, H.; Parveen, T.; Ahmad, A.; Oves, M.; Ismail, I.M.I.; Qari, H.A.; Umar, K.; Mohamad Ibrahim, M.N. Recent Advances in Metal Decorated Nanomaterials and Their Various Biological Applications: A Review. Front. Chem. 2020, 8, 341. [Google Scholar] [CrossRef]
- Anu Bhushani, J.; Anandharamakrishnan, C. Electrospinning and electrospraying techniques: Potential food based applications. Trends Food Sci. Technol 2014, 38, 21–33. [Google Scholar] [CrossRef]
- Giaconia, M.A.; Ramos, S.d.P.; Pereira, C.F.; Lemes, A.C.; De Rosso, V.V.; Braga, A.R.C. Overcoming restrictions of bioactive compounds biological effects in food using nanometer-sized structures. Food Hydrocoll. 2020, 107, 105939. [Google Scholar] [CrossRef]
- Villarreal-Gómez, L.J.; Cornejo-Bravo, J.M.; Vera-Graziano, R.; Grande, D. Electrospinning as a powerful technique for biomedical applications: A critically selected survey. J Biomater Sci Polym Ed 2016, 27, 157–176. [Google Scholar] [CrossRef] [PubMed]
- Yaqoob, A.A.; Ahmad, A.; Ibrahim, M.N.M.; Rashid, M. 12—Chitosan-based nanocomposites for gene delivery: Application and future perspectives. In Polysaccharide-Based Nanocomposites for Gene Delivery and Tissue Engineering; Bhawani, S.A., Karim, Z., Jawaid, M., Eds.; Woodhead Publishing: Amsterdam, The Netherlands, 2021; pp. 245–262. [Google Scholar]
- Juncos Bombin, A.D.; Dunne, N.J.; McCarthy, H.O. Electrospinning of natural polymers for the production of nanofibres for wound healing applications. Mater. Sci. Eng. C 2020, 114, 110994. [Google Scholar] [CrossRef]
- Huang, Z.-M.; Zhang, Y.Z.; Kotaki, M.; Ramakrishna, S. A review on polymer nanofibers by electrospinning and their applications in nanocomposites. Compos. Sci. Technol. 2003, 63, 2223–2253. [Google Scholar] [CrossRef]
- Panda, P.K.; Dash, P.; Yang, J.-M.; Chang, Y.-H. Development of chitosan, graphene oxide, and cerium oxide composite blended films: Structural, physical, and functional properties. Cellulose 2022. [Google Scholar] [CrossRef]
- Ehrlich, H.; Maldonado, M.; Spindler, K.-d.; Eckert, C.; Hanke, T.; Born, R.; Goebel, C.; Simon, P.; Heinemann, S.; Worch, H. First evidence of chitin as a component of the skeletal fibers of marine sponges. Part, I. Verongidae (demospongia: Porifera). J. Exp. Zool. B Mol. Dev. Evol. 2007, 308B, 347–356. [Google Scholar] [CrossRef]
- Mati-Baouche, N.; Elchinger, P.-H.; de Baynast, H.; Pierre, G.; Delattre, C.; Michaud, P. Chitosan as an adhesive. Eur. Polym. J. 2014, 60, 198–212. [Google Scholar] [CrossRef]
- Moussian, B. Chitin: Structure, Chemistry and Biology. In Targeting Chitin-Containing Organisms; Yang, Q., Fukamizo, T., Eds.; Springer: Singapore, 2019; pp. 5–18. [Google Scholar]
- Panda, P.K.; Yang, J.-M.; Chang, Y.-H. Preparation and characterization of ferulic acid-modified water soluble chitosan and poly (γ-glutamic acid) polyelectrolyte films through layer-by-layer assembly towards protein adsorption. Int. J. Biol. Macromol. 2021, 171, 457–464. [Google Scholar] [CrossRef]
- Avelelas, F.; Horta, A.; Pinto, L.F.V.; Cotrim Marques, S.; Marques Nunes, P.; Pedrosa, R.; Leandro, S.M. Antifungal and Antioxidant Properties of Chitosan Polymers Obtained from Nontraditional Polybius henslowii Sources. Mar. Drugs 2019, 17, 239. [Google Scholar] [CrossRef] [PubMed] [Green Version]
- Gu, B.K.; Park, S.J.; Kim, M.S.; Lee, Y.J.; Kim, J.-I.; Kim, C.-H. Gelatin blending and sonication of chitosan nanofiber mats produce synergistic effects on hemostatic functions. Int. J. Biol. Macromol. 2016, 82, 89–96. [Google Scholar] [CrossRef]
- Minet, E.P.; O’Carroll, C.; Rooney, D.; Breslin, C.; McCarthy, C.P.; Gallagher, L.; Richards, K.G. Slow delivery of a nitrification inhibitor (dicyandiamide) to soil using a biodegradable hydrogel of chitosan. Chemosphere 2013, 93, 2854–2858. [Google Scholar] [CrossRef]
- Zhang, W.; Zhang, J.; Jiang, Q.; Xia, W. The hypolipidemic activity of chitosan nanopowder prepared by ultrafine milling. Carbohydr. Polym. 2013, 95, 487–491. [Google Scholar] [CrossRef]
- Karim, Z.; Mathew, A.P.; Grahn, M.; Mouzon, J.; Oksman, K. Nanoporous membranes with cellulose nanocrystals as functional entity in chitosan: Removal of dyes from water. Carbohydr. Polym. 2014, 112, 668–676. [Google Scholar] [CrossRef] [PubMed]
- Gomaa, Y.A.; El-Khordagui, L.K.; Boraei, N.A.; Darwish, I.A. Chitosan microparticles incorporating a hydrophilic sunscreen agent. Carbohydr. Polym. 2010, 81, 234–242. [Google Scholar] [CrossRef]
- Bonilla, J.; Fortunati, E.; Atarés, L.; Chiralt, A.; Kenny, J.M. Physical, structural and antimicrobial properties of poly vinyl alcohol–chitosan biodegradable films. Food Hydrocoll. 2014, 35, 463–470. [Google Scholar] [CrossRef]
- Panda, P.K.; Yang, J.-M.; Chang, Y.-H.; Su, W.-W. Modification of different molecular weights of chitosan by p-Coumaric acid: Preparation, characterization and effect of molecular weight on its water solubility and antioxidant property. Int. J. Biol. Macromol. 2019, 136, 661–667. [Google Scholar] [CrossRef]
- Tonda-Turo, C.; Ruini, F.; Ramella, M.; Boccafoschi, F.; Gentile, P.; Gioffredi, E.; Falvo D’Urso Labate, G.; Ciardelli, G. Non-covalently crosslinked chitosan nanofibrous mats prepared by electrospinning as substrates for soft tissue regeneration. Carbohydr. Polym. 2017, 162, 82–92. [Google Scholar] [CrossRef] [Green Version]
- Kouchak, M.; Ameri, A.; Naseri, B.; Kargar Boldaji, S. Chitosan and polyvinyl alcohol composite films containing nitrofurazone: Preparation and evaluation. Iran. J. Basic Med. Sci. 2014, 17, 14–20. [Google Scholar] [CrossRef]
- Deng, L.; Taxipalati, M.; Zhang, A.; Que, F.; Wei, H.; Feng, F.; Zhang, H. Electrospun Chitosan/Poly(ethylene oxide)/Lauric Arginate Nanofibrous Film with Enhanced Antimicrobial Activity. J. Agric. Food Chem. 2018, 66, 6219–6226. [Google Scholar] [CrossRef]
- Bazli, L.; Khavandi, A.; Boutorabi, M.A.; Karrabi, M. Correlation between viscoelastic behavior and morphology of nanocomposites based on SR/EPDM blends compatibilized by maleic anhydride. Polymer 2017, 113, 156–166. [Google Scholar] [CrossRef]
- Panda, P.K.; Yang, J.-M.; Chang, Y.-H. Water-induced shape memory behavior of poly (vinyl alcohol) and p-coumaric acid-modified water-soluble chitosan blended membrane. Carbohydr. Polym. 2021, 257, 117633. [Google Scholar] [CrossRef]
- Muppalla, S.R.; Kanatt, S.R.; Chawla, S.P.; Sharma, A. Carboxymethyl cellulose–polyvinyl alcohol films with clove oil for active packaging of ground chicken meat. Food Packag. Shelf Life 2014, 2, 51–58. [Google Scholar] [CrossRef]
- Nwabor, O.F.; Singh, S.; Paosen, S.; Vongkamjan, K.; Voravuthikunchai, S.P. Enhancement of food shelf life with polyvinyl alcohol-chitosan nanocomposite films from bioactive Eucalyptus leaf extracts. Food Biosci. 2020, 36, 100609. [Google Scholar] [CrossRef]
- Nataraj, D.; Reddy, R.; Reddy, N. Crosslinking electrospun poly (vinyl) alcohol fibers with citric acid to impart aqueous stability for medical applications. Eur. Polym. J. 2020, 124, 109484. [Google Scholar] [CrossRef]
- Fathollahipour, S.; Abouei Mehrizi, A.; Ghaee, A.; Koosha, M. Electrospinning of PVA/chitosan nanocomposite nanofibers containing gelatin nanoparticles as a dual drug delivery system. J. Biomed. Mater. Res. 2015, 103, 3852–3862. [Google Scholar] [CrossRef] [PubMed]
- Koosha, M.; Mirzadeh, H. Electrospinning, mechanical properties, and cell behavior study of chitosan/PVA nanofibers. J. Biomed. Mater. Res. 2015, 103, 3081–3093. [Google Scholar] [CrossRef] [PubMed]
- Kamoun, E.A.; Kenawy, E.-R.S.; Chen, X. A review on polymeric hydrogel membranes for wound dressing applications: PVA-based hydrogel dressings. J. Adv. Res. 2017, 8, 217–233. [Google Scholar] [CrossRef]
- Borges, C.; Colaço, R.; Paula Serro, A. Poly(vinyl alcohol)-based hydrogels for joint prosthesis. Ann. Med. 2019, 51, 105. [Google Scholar] [CrossRef] [Green Version]
- Khan, M.M.R.; Tsukada, M.; Zhang, X.; Morikawa, H. Preparation and characterization of electrospun nanofibers based on silk sericin powders. J. Mater. Sci. 2013, 48, 3731–3736. [Google Scholar] [CrossRef]
- Zhao, R.; Li, X.; Sun, B.; Zhang, Y.; Zhang, D.; Tang, Z.; Chen, X.; Wang, C. Electrospun chitosan/sericin composite nanofibers with antibacterial property as potential wound dressings. Int. J. Biol. Macromol. 2014, 68, 92–97. [Google Scholar] [CrossRef]
- Ahmed, R.; Tariq, M.; Ali, I.; Asghar, R.; Noorunnisa Khanam, P.; Augustine, R.; Hasan, A. Novel electrospun chitosan/polyvinyl alcohol/zinc oxide nanofibrous mats with antibacterial and antioxidant properties for diabetic wound healing. Int. J. Biol. Macromol. 2018, 120, 385–393. [Google Scholar] [CrossRef]
- Adeli, H.; Khorasani, M.T.; Parvazinia, M. Wound dressing based on electrospun PVA/chitosan/starch nanofibrous mats: Fabrication, antibacterial and cytocompatibility evaluation and in vitro healing assay. Int. J. Biol. Macromol. 2019, 122, 238–254. [Google Scholar] [CrossRef]
- Wang, M.; Roy, A.K.; Webster, T.J. Development of Chitosan/Poly(Vinyl Alcohol) Electrospun Nanofibers for Infection Related Wound Healing. Front. Physiol. 2017, 7, 683. [Google Scholar] [CrossRef]
- Tolaymat, T.M.; El Badawy, A.M.; Genaidy, A.; Scheckel, K.G.; Luxton, T.P.; Suidan, M. An evidence-based environmental perspective of manufactured silver nanoparticle in syntheses and applications: A systematic review and critical appraisal of peer-reviewed scientific papers. Sci. Total Environ. 2010, 408, 999–1006. [Google Scholar] [CrossRef] [PubMed] [Green Version]
- Yaqoob, A.A.; Umar, K.; Ibrahim, M.N.M. Silver nanoparticles: Various methods of synthesis, size affecting factors and their potential applications—A review. Appl. Nanosci. 2020, 10, 1369–1378. [Google Scholar] [CrossRef]
- Zhang, Y.; Lee, M.W.; An, S.; Sinha-Ray, S.; Khansari, S.; Joshi, B.; Hong, S.; Hong, J.-H.; Kim, J.-J.; Pourdeyhimi, B.; et al. Antibacterial activity of photocatalytic electrospun titania nanofiber mats and solution-blown soy protein nanofiber mats decorated with silver nanoparticles. Catal. Commun. 2013, 34, 35–40. [Google Scholar] [CrossRef]
- Saatchi, A.; Arani, A.R.; Moghanian, A.; Mozafari, M. Cerium-doped bioactive glass-loaded chitosan/polyethylene oxide nanofiber with elevated antibacterial properties as a potential wound dressing. Ceram. Int. 2021, 47, 9447–9461. [Google Scholar] [CrossRef]
- George, G.; Senthil, T.; Luo, Z.; Anandhan, S. 22—Sol-gel electrospinning of diverse ceramic nanofibers and their potential applications. In Electrospun Polymers and Composites; Dong, Y., Baji, A., Ramakrishna, S., Eds.; Woodhead Publishing: Amsterdam, The Netherlands, 2021; pp. 689–764. [Google Scholar]
- Shalumon, K.T.; Anulekha, K.H.; Nair, S.V.; Nair, S.V.; Chennazhi, K.P.; Jayakumar, R. Sodium alginate/poly(vinyl alcohol)/nano ZnO composite nanofibers for antibacterial wound dressings. Int. J. Biol. Macromol. 2011, 49, 247–254. [Google Scholar] [CrossRef]
- Santiago-Castillo, K.; Del Angel-López, D.; Torres-Huerta, A.M.; Domínguez-Crespo, M.A.; Palma-Ramírez, D.; Willcock, H.; Brachetti-Sibaja, S.B. Effect on the processability, structure and mechanical properties of highly dispersed in situ ZnO:CS nanoparticles into PVA electrospun fibers. J. Mater. Res. Technol. 2021, 11, 929–945. [Google Scholar] [CrossRef]
- Nada, A.A.; El Aref, A.T.; Sharaf, S.S. The synthesis and characterization of zinc-containing electrospun chitosan/gelatin derivatives with antibacterial properties. Int. J. Biol. Macromol. 2019, 133, 538–544. [Google Scholar] [CrossRef] [PubMed]
- Ghasemian Lemraski, E.; Jahangirian, H.; Dashti, M.; Khajehali, E.; Sharafinia, S.; Rafiee-Moghaddam, R.; Webster, T.J. Antimicrobial Double-Layer Wound Dressing Based on Chitosan/Polyvinyl Alcohol/Copper: In vitro and in vivo Assessment. Int. J. Nanomed. 2021, 16, 223–235. [Google Scholar] [CrossRef]
- Mohandas, A.; Deepthi, S.; Biswas, R.; Jayakumar, R. Chitosan based metallic nanocomposite scaffolds as antimicrobial wound dressings. Bioact. Mater. 2018, 3, 267–277. [Google Scholar] [CrossRef]
- Mohamady Hussein, M.A.; Ulag, S.; Abo Dena, A.S.; Sahin, A.; Grinholc, M.; Gunduz, O.; El-Sherbiny, I.; Megahed, M. Chitosan/Gold Hybrid Nanoparticles Enriched Electrospun PVA Nanofibrous Mats for the Topical Delivery of Punica granatum L. Extract: Synthesis, Characterization, Biocompatibility and Antibacterial Properties. Int. J. Nanomed. 2021, 16, 5133–5151. [Google Scholar] [CrossRef]
- Li, S.; Zhang, R.; Xie, J.; Sameen, D.E.; Ahmed, S.; Dai, J.; Qin, W.; Li, S.; Liu, Y. Electrospun antibacterial poly(vinyl alcohol)/Ag nanoparticles membrane grafted with 3,3′,4,4′-benzophenone tetracarboxylic acid for efficient air filtration. Appl. Surf. Sci. 2020, 533, 147516. [Google Scholar] [CrossRef]
- Nadworny, P.L.; Wang, J.; Tredget, E.E.; Burrell, R.E. Anti-inflammatory activity of nanocrystalline silver-derived solutions in porcine contact dermatitis. J. Inflamm. 2010, 7, 13. [Google Scholar] [CrossRef] [PubMed] [Green Version]
- Kharaghani, D.; Khan, M.Q.; Tamada, Y.; Ogasawara, H.; Inoue, Y.; Saito, Y.; Hashmi, M.; Kim, I.S. Fabrication of electrospun antibacterial PVA/Cs nanofibers loaded with CuNPs and AgNPs by an in-situ method. Polym. Test. 2018, 72, 315–321. [Google Scholar] [CrossRef]
- Abdelgawad, A.M.; Hudson, S.M.; Rojas, O.J. Antimicrobial wound dressing nanofiber mats from multicomponent (chitosan/silver-NPs/polyvinyl alcohol) systems. Carbohydr. Polym. 2014, 100, 166–178. [Google Scholar] [CrossRef] [PubMed]
- Jahan, F.; Mathad, R.D.; Farheen, S. Effect of mechanical strength on chitosan-pva blend through ionic crosslinking for food packaging application. Mater. Today Proc. 2016, 3, 3689–3696. [Google Scholar] [CrossRef]
- Potara, M.; Jakab, E.; Damert, A.; Popescu, O.; Canpean, V.; Astilean, S. Synergistic antibacterial activity of chitosan–silver nanocomposites onStaphylococcus aureus. Nanotechnology 2011, 22, 135101. [Google Scholar] [CrossRef] [PubMed]
- Jang, M.-K.; Kong, B.-G.; Jeong, Y.-I.; Lee, C.H.; Nah, J.-W. Physicochemical characterization of α-chitin, β-chitin, and γ-chitin separated from natural resources. J. Polym. Sci. Part A-1 Polym. Chem. 2004, 42, 3423–3432. [Google Scholar] [CrossRef]
- Cartier, N.; Domard, A.; Chanzy, H. Single crystals of chitosan. Int. J. Biol. Macromol. 1990, 12, 289–294. [Google Scholar] [CrossRef]
- Soleimani, F.F.; Saleh, T.; Shojaosadati, S.A.; Poursalehi, R. Green Synthesis of Different Shapes of Silver Nanostructures and Evaluation of Their Antibacterial and Cytotoxic Activity. Bionanoscience 2018, 8, 72–80. [Google Scholar] [CrossRef]
- Dash, P.; Yang, J.-M.; Lin, H.; Lin, A.S. Preparation and characterization of zinc gallate phosphor for electrochemical luminescence. J. Lumin. 2020, 228, 117593. [Google Scholar] [CrossRef]
- Biswal, A.K.; Panda, P.K.; Yang, J.-M.; Misra, P.K. Isolation, process optimisation and characterisation of the protein from the de-oiled cake flour of Madhuca latifolia. IET Nanobiotechnol. 2020, 14, 654–661. [Google Scholar] [CrossRef] [PubMed]
- Chen, Z.; Zhang, X.; Cao, H.; Huang, Y. Chitosan-capped silver nanoparticles as a highly selective colorimetric probe for visual detection of aromatic ortho-trihydroxy phenols. Analyst 2013, 138, 2343–2349. [Google Scholar] [CrossRef] [PubMed]
- Brause, R.; Möltgen, H.; Kleinermanns, K. Characterization of laser-ablated and chemically reduced silver colloids in aqueous solution by UV/VIS spectroscopy and STM/SEM microscopy. Appl. Phys. B 2002, 75, 711–716. [Google Scholar] [CrossRef]
- Kerker, M. The optics of colloidal silver: Something old and something new. J. Colloid Interface Sci. 1985, 105, 297–314. [Google Scholar] [CrossRef]
- Zamiri, R.; Zakaria, A.; Ahangar, H.; Darroudi, M.; Zamiri, G.; Rizwan, Z.; Drummen, G. The effect of laser repetition rate on the LASiS synthesis of biocompatible silver nanoparticles in aqueous starch solution. Int. J. Nanomed. 2013, 8, 233–244. [Google Scholar] [CrossRef] [Green Version]
- Barani, H.; Montazer, M.; Toliyat, T.; Samadi, N. Synthesis of Ag-liposome nano composites. J. Liposome Res. 2010, 20, 323–329. [Google Scholar] [CrossRef] [PubMed]
- Paramelle, D.; Sadovoy, A.; Gorelik, S.; Free, P.; Hobley, J.; Fernig, D.G. A rapid method to estimate the concentration of citrate capped silver nanoparticles from UV-visible light spectra. Analyst 2014, 139, 4855–4861. [Google Scholar] [CrossRef] [PubMed]
- Marassi, V.; Casolari, S.; Roda, B.; Zattoni, A.; Reschiglian, P.; Panzavolta, S.; Tofail, S.A.M.; Ortelli, S.; Delpivo, C.; Blosi, M.; et al. Hollow-fiber flow field-flow fractionation and multi-angle light scattering investigation of the size, shape and metal-release of silver nanoparticles in aqueous medium for nano-risk assessment. J. Pharm. Biomed. Anal. 2015, 106, 92–99. [Google Scholar] [CrossRef] [PubMed]
- Wongpreecha, J.; Polpanich, D.; Suteewong, T.; Kaewsaneha, C.; Tangboriboonrat, P. One-pot, large-scale green synthesis of silver nanoparticles-chitosan with enhanced antibacterial activity and low cytotoxicity. Carbohydr. Polym. 2018, 199, 641–648. [Google Scholar] [CrossRef] [PubMed]
- Potara, M.; Baia, M.; Farcău, C.; Astilean, S. Chitosan-coated anisotropic silver nanoparticles as a SERS substrate for single-molecule detection. Nanotechnology 2012, 23, 055501. [Google Scholar] [CrossRef] [PubMed]
- Kalaivani, R.; Maruthupandy, M.; Muneeswaran, T.; Hameedha Beevi, A.; Anand, M.; Ramakritinan, C.M.; Kumaraguru, A.K. Synthesis of chitosan mediated silver nanoparticles (Ag NPs) for potential antimicrobial applications. Front. Life Sci. 2018, 2, 30–35. [Google Scholar] [CrossRef]
- Wahab, R.; Ansari, S.G.; Kim, Y.S.; Song, M.; Shin, H.-S. The role of pH variation on the growth of zinc oxide nanostructures. Appl. Surf. Sci. 2009, 255, 4891–4896. [Google Scholar] [CrossRef]
- Shekhar, A. Size-controlled silver nanoparticles synthesized over the range 5–100 nm using the same protocol and their antibacterial efficacy. RSC Adv. 2013, 4, 3974–3983. [Google Scholar] [CrossRef] [Green Version]
- Abbas, W.A.; Sharafeldin, I.M.; Omar, M.M.; Allam, N.K. Novel mineralized electrospun chitosan/PVA/TiO2 nanofibrous composites for potential biomedical applications: Computational and experimental insights. Nanoscale Adv. 2020, 2, 1512–1522. [Google Scholar] [CrossRef] [Green Version]
- Khan, M.Q.; Kharaghani, D.; Nishat, N.; Shahzad, A.; Hussain, T.; Khatri, Z.; Zhu, C.; Kim, I.S. Preparation and characterizations of multifunctional PVA/ZnO nanofibers composite membranes for surgical gown application. J. Mater. Res. Technol. 2019, 8, 1328–1334. [Google Scholar] [CrossRef]
- Liu, Y.; Liu, Y.; Liao, N.; Cui, F.; Park, M.; Kim, H.-Y. Fabrication and durable antibacterial properties of electrospun chitosan nanofibers with silver nanoparticles. Int. J. Biol. Macromol. 2015, 79, 638–643. [Google Scholar] [CrossRef] [PubMed]
- Li, Z.; Yang, F.; Yang, R. Synthesis and characterization of chitosan derivatives with dual-antibacterial functional groups. Int. J. Biol. Macromol. 2015, 75, 378–387. [Google Scholar] [CrossRef] [PubMed]
- Li, J.; Zhuang, S. Antibacterial activity of chitosan and its derivatives and their interaction mechanism with bacteria: Current state and perspectives. Eur. Polym. J. 2020, 138, 109984. [Google Scholar] [CrossRef]

| Electrospun Nanofibers | HIT (GPa) | EIT (MPa) | Inhibition Halo | Reference | |
|---|---|---|---|---|---|
| E. coli (mm) | S. aureus (mm) | ||||
| PVA | 16 ± 1.32 | 2.6 ± 0.36 | Not active | Not active | This work |
| Neat PVA | 0.25 × 10−3 | - | Not active | Not active | [78] |
| PVA-CTS | 32 ± 2.47 | 3.4 ± 0.40 | 20.0 | 20.0 | This work |
| PVA-CTS | 3.65 × 10−3 (tensile strength) | -- | 7.0 | 7.0 | [79] |
| PVA-CTS | - | - | Less antibacterial activity than PVA-CS-Ag NPs | - | [57] |
| PVA-CTS | - | - | 14.1 | 5.4 | [40] |
| PVA-CTS | <0.05 (hardness) | 100 (elastic modulus) | - | - | [77] |
| PVA-ZnO (5 wt%) | Larger than neat PVA (bearing load) | Smaller than neat PVA (elongation) | 1 | 1.3 | [78] |
| PVA-CTS-Ag NPs | 152 ± 5.2 | 25 ± 9.88 | 22.0 | 20.0 | This work |
| PVA-CTS-Ag NPs (0.5 wt%) | 4.52 MPa (tensile strength) | - | 13.3 | 14.3 | [79] |
| CTS-PVA-nHA-Ag NPs | Greater antibacterial activity than CTS-PVA-nHA-Cu NPs | - | [56] | ||
| PVA-CTS-Ag NPs | - | - | Greater antibacterial activity than PVA-CTS | ||
| PVA-CTS-ZnO NPs | 42 ± 2.23 | 2.1 ± 0.16 | 20 mm | 20 mm | [49] |
| CTS-PVA-ZnO NPs | - | - | 21.8 | 21.5 | [40] |
| PVA-CTS-TiO2 NPs | <0.025 (hardness) | 170 (elastic modulus) | - | - | [77] |
Publisher’s Note: MDPI stays neutral with regard to jurisdictional claims in published maps and institutional affiliations. |
© 2022 by the authors. Licensee MDPI, Basel, Switzerland. This article is an open access article distributed under the terms and conditions of the Creative Commons Attribution (CC BY) license (https://creativecommons.org/licenses/by/4.0/).
Share and Cite
Santiago-Castillo, K.; Torres-Huerta, A.M.; del Ángel-López, D.; Domínguez-Crespo, M.A.; Dorantes-Rosales, H.; Palma-Ramírez, D.; Willcock, H. In Situ Growth of Silver Nanoparticles on Chitosan Matrix for the Synthesis of Hybrid Electrospun Fibers: Analysis of Microstructural and Mechanical Properties. Polymers 2022, 14, 674. https://doi.org/10.3390/polym14040674
Santiago-Castillo K, Torres-Huerta AM, del Ángel-López D, Domínguez-Crespo MA, Dorantes-Rosales H, Palma-Ramírez D, Willcock H. In Situ Growth of Silver Nanoparticles on Chitosan Matrix for the Synthesis of Hybrid Electrospun Fibers: Analysis of Microstructural and Mechanical Properties. Polymers. 2022; 14(4):674. https://doi.org/10.3390/polym14040674
Chicago/Turabian StyleSantiago-Castillo, Karina, Aidé Minerva Torres-Huerta, Deyanira del Ángel-López, Miguel Antonio Domínguez-Crespo, Héctor Dorantes-Rosales, Diana Palma-Ramírez, and Helen Willcock. 2022. "In Situ Growth of Silver Nanoparticles on Chitosan Matrix for the Synthesis of Hybrid Electrospun Fibers: Analysis of Microstructural and Mechanical Properties" Polymers 14, no. 4: 674. https://doi.org/10.3390/polym14040674
APA StyleSantiago-Castillo, K., Torres-Huerta, A. M., del Ángel-López, D., Domínguez-Crespo, M. A., Dorantes-Rosales, H., Palma-Ramírez, D., & Willcock, H. (2022). In Situ Growth of Silver Nanoparticles on Chitosan Matrix for the Synthesis of Hybrid Electrospun Fibers: Analysis of Microstructural and Mechanical Properties. Polymers, 14(4), 674. https://doi.org/10.3390/polym14040674

